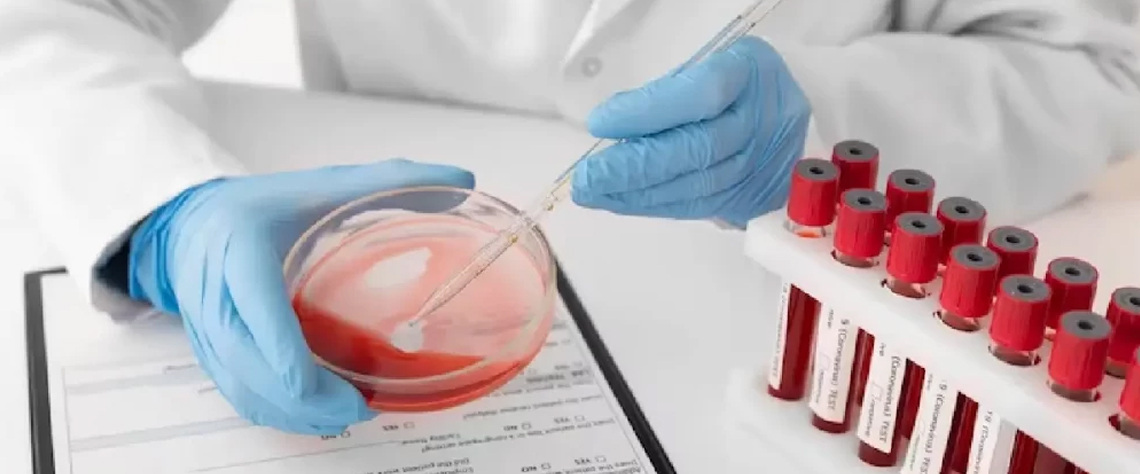

بهترین مرکز چکاپ کامل مردان در تهران کجاست؟
سلامت مردان یکی از مهمترین عوامل کیفیت زندگی و پیشگیری از بیماریهای مزمن است. بسیاری از بیماریها، از جمله مشکلات قلبی، کبدی، دیابت یا اختلالات پروستات، در مراحل اولیه علامت مشخصی ندارند و تنها با چکاپ منظم و کامل مردان میتوان آنها را بهموقع شناسایی کرد.
مراجعه حضوری به مراکز درمانی، مشکلاتی مانند صفهای طولانی، آلودگی محیط و ترافیک را به همراه دارد. به همین دلیل، مجموعه لیما طب با ارائه خدمات چکاپ در منزل، امکان دسترسی آسان، سریع و مطمئن به آزمایشها و مشاورههای تخصصی را فراهم کرده است.
در این گزارش رسانهای، به بررسی اهمیت چکاپ مردان، شاخصهای اصلی، نکات قبل و بعد از آزمایش و ویژگیهای بهترین مراکز چکاپ در تهران میپردازیم تا مخاطبان بتوانند تصمیمی آگاهانه و بهصرفه بگیرند.
اهمیت چکاپ کامل مردان و پیشگیری از بیماریها
چکاپ کامل مردان، یکی از ابزارهای کلیدی پیشگیری و تشخیص زودهنگام بیماریها است. بسیاری از بیماریهای جدی در مردان، مانند بیماریهای قلبی، دیابت، فشار خون و سرطان پروستات در مراحل اولیه بدون علامت هستند و تنها با آزمایشهای دورهای قابل شناساییاند.
چکاپ منظم نهتنها سلامت فیزیکی بلکه سلامت روانی فرد را نیز بهبود میبخشد، زیرا مردان با آگاهی از وضعیت جسمانی خود، سبک زندگی سالمتری اتخاذ میکنند.
نقش چکاپ منظم در تشخیص زودهنگام بیماریها
تشخیص بهموقع بیماریها میتواند درمان موفقتر و هزینههای کمتری داشته باشد. برای مثال، سرطان پروستات اگر در مراحل اولیه شناسایی شود، درمان سادهتر و موفقیتآمیزتری دارد. چکاپ منظم شامل آزمایش خون، بررسی فشار خون و سطح کلسترول، تصویربرداری و مشاوره پزشکی است.
مطالعات نشان میدهد مردانی که سالانه چکاپ میشوند، ریسک بروز عوارض شدید ناشی از بیماریهای مزمن را تا ۳۰ درصد کاهش میدهند.
تاثیر بررسی دورهای بر سلامت قلب و کبد و پروستات
آزمایشهای منظم شامل بررسی آنزیمهای کبدی، سطح چربی خون و پروتئینهای قلبی است. این آزمایشها به شناسایی بیماریهای خاموش کبد، کلسترول بالا و مشکلات قلبی کمک میکنند.
با چکاپ منظم، مردان میتوانند با تغییر سبک زندگی، رژیم غذایی و مشاوره پزشکی، احتمال ابتلا به بیماریهای جدی را بهطور چشمگیری کاهش دهند.

شاخصهای اصلی در یک چکاپ کامل مردان
یک چکاپ کامل مردان شامل مجموعهای از آزمایشها و بررسیهای تخصصی است که تمام ارگانهای حیاتی را پوشش میدهد. از خون و ادرار گرفته تا تصویربرداری و تست هورمونها، هر شاخص نقشی حیاتی در تشخیص بیماریها دارد.
آزمایشهای خون و ادرار و تصویربرداریهای ضروری
آزمایش خون شامل شمارش سلولهای خونی، بررسی آنزیمهای کبدی و کلیوی، میزان قند و چربی خون است. آزمایش ادرار، عملکرد کلیه و سیستم ادراری را بررسی میکند. تصویربرداریها مانند سونوگرافی پروستات و قلب، ساختار و عملکرد اندامها را به دقت نشان میدهند و اختلالات احتمالی را شناسایی میکنند.
بررسی هورمونها و عملکرد کلیه و سطح کلسترول
سطح تستوسترون، هورمون تیروئید و دیگر هورمونها نقش مهمی در سلامت مردان دارند. عدم تعادل هورمونی میتواند باعث کاهش انرژی، مشکلات جنسی و اختلالات متابولیک شود. همچنین بررسی عملکرد کلیهها و میزان کلسترول خون به پیشگیری از بیماریهای مزمن کمک میکند.

عوامل مؤثر در انتخاب بهترین مرکز چکاپ مردان
انتخاب مرکز مناسب برای چکاپ مردان، به کیفیت خدمات، تجربه پزشکان و تجهیزات مورد استفاده بستگی دارد. مرکزی که استانداردهای بهداشتی و پروتکلهای تشخیصی را رعایت کند، میتواند سلامت فرد را به شکل قابل اعتماد بررسی کند.
تخصص پزشکان و تجربه پرسنل درمانی
پزشکان و پرستاران با تجربه، در تشخیص دقیق نتایج آزمایش و ارائه مشاوره مناسب نقش کلیدی دارند. در مجموعه لیما طب، تیم پزشکی شامل اساتید برجسته و متخصصان باتجربه است که تجربه بیش از سی سال در حوزه خدمات درمانی و بهداشتی دارند.
تجهیزات پیشرفته و رعایت استانداردهای بهداشتی
استفاده از دستگاههای پیشرفته آزمایشگاهی و تصویربرداری دیجیتال دقت تشخیص را افزایش میدهد. همچنین رعایت پروتکلهای بهداشتی، ضدعفونی تجهیزات و تستهای استاندارد، از بروز خطا و انتقال بیماری جلوگیری میکند.
مزایای چکاپ در منزل نسبت به مراجعه حضوری
خدمات چکاپ در منزل، تجربهای راحت و امن برای بیماران ایجاد میکند. مردانی که مشغله کاری دارند یا به دلیل مشکلات ترافیک و کرونا ترجیح میدهند از خانه خارج نشوند، میتوانند از خدمات آزمایشگاهی و پرستاری در محل بهرهمند شوند.
صرفهجویی در زمان و کاهش استرس بیمار
با ارائه خدمات در منزل، نیاز به صرف وقت برای رفتوآمد و انتظار در صفها کاهش مییابد. این موضوع استرس بیمار را کم میکند و امکان بررسی دقیقتر و همکاری بیشتر بیمار با پزشک فراهم میشود.
کنترل بهتر شرایط محیطی و رعایت بهداشت
در منزل، بیمار در محیط امن و آشنا قرار دارد. رعایت بهداشت توسط تیم لیما طب، استفاده از تجهیزات استریل و پروتکلهای دقیق، ریسک ابتلا به بیماریهای واگیردار را کاهش میدهد.
نکات مهم قبل و بعد از چکاپ کامل مردان
رعایت نکات قبل و بعد از چکاپ، دقت نتایج آزمایشها را افزایش میدهد و فرآیند درمان را تسهیل میکند. آمادهسازی مناسب بدن و پیگیری توصیههای پزشک پس از آزمایش، از اهمیت بالایی برخوردار است.
آمادهسازی بدن و رعایت نکات تغذیهای قبل از آزمایش
قبل از آزمایش خون، ناشتا بودن حدود ۸ تا ۱۲ ساعت توصیه میشود. همچنین مصرف آب کافی، پرهیز از ورزش سنگین و خودداری از مصرف داروهای غیرضروری، میتواند دقت آزمایشها را بهبود بخشد.
رعایت دستورات پزشک و پیگیری نتایج پس از آزمایش
پس از دریافت نتایج، مشاوره با پزشک جهت تفسیر دقیق و برنامهریزی درمان یا تغییر سبک زندگی ضروری است. رعایت توصیههای پزشک و ادامه بررسیهای دورهای، سلامت مردان را در بلندمدت تضمین میکند.
چرا لیما طب بهترین انتخاب برای چکاپ کامل مردان است؟
مجموعه لیما طب با بیش از سی سال سابقه در حوزه خدمات درمانی و بهداشتی، تجربهای بینظیر در ارائه خدمات چکاپ کامل مردان دارد. تیم پزشکی شامل اساتید و متخصصان برجسته است که با دانش روز و تجهیزات مدرن، دقت و کیفیت خدمات را تضمین میکنند.
ویژگی منحصر به فرد لیما طب، ارائه خدمات در منزل یا محل دلخواه بیمار است، که علاوه بر صرفهجویی در زمان، تجربهای راحت، امن و بهداشتی را برای کاربران فراهم میکند.
تجربه بیش از ۳۰ سال پزشکان و پرستاران متخصص
کارشناسان و پزشکان لیما طب، با تجربه طولانی در حوزه مراقبتهای پیشگیرانه و درمانی، قادرند هر چکاپ را به شکل تخصصی انجام دهند. این تجربه، تشخیص سریع و دقیق را تضمین میکند و به بیماران اطمینان میدهد که تمام مراحل چکاپ مطابق با استانداردهای بینالمللی انجام میشود.
خدمات سریع و با کیفیت و مقرون به صرفه
لیما طب با هدف دسترسی آسان و قیمت مناسب، بستههای مختلف چکاپ مردان را ارائه میدهد. این بستهها شامل آزمایشهای پایه، تخصصی و تصویربرداری است و بیماران میتوانند با انتخاب بسته مناسب، بهترین کیفیت با کمترین هزینه را تجربه کنند.
معرفی خدمات چکاپ مردان در منزل توسط لیما طب
لیما طب خدمات گستردهای در منزل ارائه میدهد که شامل نمونهبرداری خون، تستهای تخصصی، پرستاری و تزریقات میشود. این خدمات به ویژه برای مردانی که مشغله کاری دارند یا توانایی مراجعه حضوری ندارند، بسیار مناسب است.
نمونهبرداری خون و تست PCR و آزمایشهای تخصصی
تمام آزمایشها توسط تیم حرفهای و با رعایت اصول استریل انجام میشود. از جمله خدمات مهم میتوان به نمونهبرداری خون، تستهای هورمونی، سطح کلسترول و تست PCR اشاره کرد. تیم پرستاری آموزش دیده، فرآیند نمونهگیری را به شکل بدون درد و دقیق انجام میدهد.
ارائه خدمات پرستاری و تزریقات در محل
علاوه بر چکاپ، خدمات پرستاری شامل تزریقات، سرمتراپی و مراقبتهای بعد از آزمایش نیز در منزل ارائه میشود. این خدمات باعث میشود بیمار بدون نگرانی و دغدغه، تمام مراحل مراقبت و بررسی سلامت خود را در محیط امن خانه انجام دهد.
روند دریافت خدمات و رزرو آنلاین در لیما طب
رزرو خدمات چکاپ در لیما طب بسیار ساده و کاربرپسند است. کاربران میتوانند از طریق وبسایت یا تماس تلفنی، وقت دلخواه خود را انتخاب کرده و نوع چکاپ موردنظر به همراه هزینه چکاپ در منزل را مشخص کنند.
نحوه رزرو وقت و انتخاب نوع چکاپ
ابتدا کاربر با مراجعه به صفحه خدمات چکاپ مردان، بسته یا آزمایش مورد نظر خود را انتخاب میکند. سپس زمان انجام خدمات در منزل یا محل کار تعیین میشود. سیستم رزرو آنلاین، امکان پرداخت امن و دریافت رسید دیجیتال را نیز فراهم میکند.
پشتیبانی تلفنی و مشاوره رایگان قبل از خدمات
قبل از انجام چکاپ، تیم پشتیبانی و مشاوره لیما طب، تمام سوالات و ابهامات کاربران را پاسخ میدهند. این مشاوره شامل تعیین نوع آزمایش، توضیح مراحل چکاپ و آمادهسازی قبل از نمونهگیری است، تا تجربهای راحت و مطمئن برای بیماران فراهم شود.
تجهیزات و فناوریهای مدرن مورد استفاده در لیما طب
لیما طب با بهرهگیری از تجهیزات پیشرفته آزمایشگاهی و فناوریهای روز، دقت و سرعت انجام چکاپها را افزایش داده است. استفاده از دستگاههای دیجیتال، تستهای اتوماتیک و استانداردهای بینالمللی، کیفیت خدمات را تضمین میکند.
استفاده از دستگاههای پیشرفته آزمایشگاهی و تصویربرداری
تمام آزمایشها با دستگاههای مدرن انجام میشود که دقت بالایی در اندازهگیری سطح هورمونها، آنزیمها و عوامل بیوشیمیایی دارند. تصویربرداریها نیز با دستگاههای سونوگرافی و تجهیزات پزشکی پیشرفته انجام میشود.
رعایت پروتکلهای بهداشتی و ایمنی در منزل
تیمهای لیما طب تمامی پروتکلهای بهداشتی را رعایت میکنند؛ تجهیزات استریل، دستکش، ماسک و ژل ضدعفونیکننده، ایمنی بیمار و پرسنل را تضمین میکند. این اقدامات باعث کاهش خطر عفونت و افزایش اعتماد بیماران میشود.
تجربه بیماران و رضایت کاربران از خدمات چکاپ مردان
رضایت بیماران، شاخص مهم کیفیت خدمات است. بیماران لیما طب از راحتی، دقت و سرعت ارائه خدمات و امکان انجام چکاپ در منزل، بازخورد بسیار مثبتی ارائه کردهاند.
نمونههای موفق و بازخورد مثبت مشتریان
بر اساس تجربه کاربران، انجام چکاپ کامل مردان در منزل، علاوه بر صرفهجویی در زمان، استرس کمتری نسبت به مراجعه حضوری ایجاد میکند. بسیاری از کاربران از دقت آزمایشها و مشاورههای تخصصی پزشکان رضایت کامل دارند.
تأثیر خدمات لیما طب بر کاهش مراجعه حضوری و راحتی بیمار
با استفاده از خدمات لیما طب، بیماران دیگر نیازی به حضور فیزیکی در آزمایشگاهها یا مراکز درمانی شلوغ ندارند. این روش باعث میشود زمان کمتری صرف شود و تجربهای امن، راحت و کارآمد برای بیمار فراهم گردد.
نتیجهگیری
چکاپ کامل مردان یکی از مهمترین ابزارهای پیشگیری و حفظ سلامت است. با انتخاب مرکز مناسب، مانند لیما طب، میتوان از تشخیص زودهنگام بیماریها، صرفهجویی در زمان و تجربهای امن و راحت بهرهمند شد. لیما طب با تیم متخصص، تجهیزات پیشرفته و خدمات در منزل، امکان دسترسی سریع و با کیفیت به چکاپ کامل مردان را فراهم کرده است.
برای رزرو وقت، مشاهده بستههای خدماتی و دریافت مشاوره تخصصی، کافی است به وبسایت رسمی لیما طب مراجعه کنید یا با شمارههای پشتیبانی تماس بگیرید. با انتخاب لیما طب، سلامت خود را در دستان متخصصان قرار دهید و تجربهای مطمئن و راحت از چکاپ کامل مردان داشته باشید.